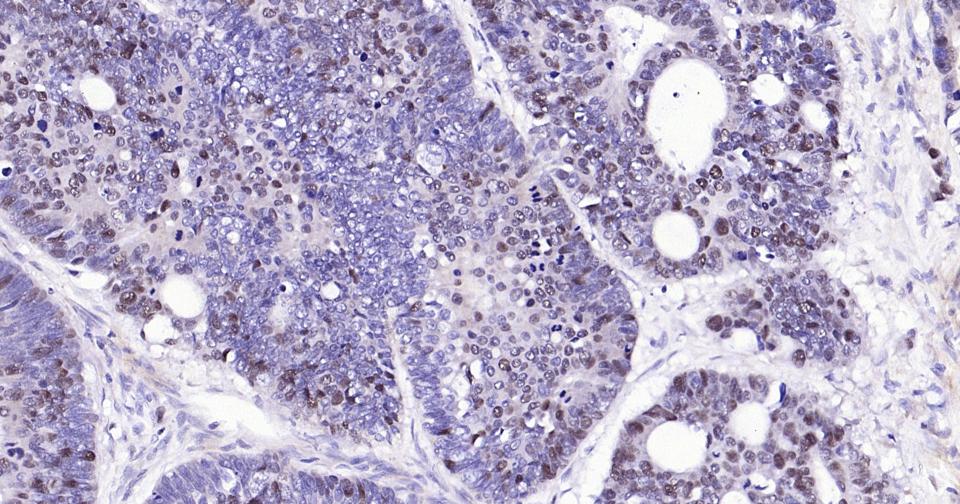
PCNA Rabbit pAb(bs-10889R)-50u

相关产品推荐更多 >

LCA5L Rabbit pAb, AP conjugated(bs-9972R-AP)-100ul
¥2980
phospho-Smad2 (Ser250) Rabbit pAb, AP conjugated(bs-7464R-AP)-100ul
¥2980
FAM129A Rabbit pAb(bs-6534R)-50ul/100ul/200ul
¥1180
C20orf31 Rabbit pAb, HRP conjugated(bs-15110R-HRP)-100ul
¥2980
phospho-Bcl2 (Thr69) Rabbit pAb, BF350 conjugated(bs-12578R-BF350)-100ul
¥2980
万千商家帮你免费找货
0 人在求购买到急需产品
- 详细信息
- 技术资料
- 应用范围:
产品信息以Bioss网站为准
- 规格:
50ul/100ul/200ul
| 规格: | 50ul | 产品价格: | ¥1180.0 |
|---|---|---|---|
| 规格: | 100ul | 产品价格: | ¥1980.0 |
| 规格: | 200ul | 产品价格: | ¥2800.0 |
| 产品编号 | bs-10889R |
| 英文名称 | PCNA Rabbit pAb |
| 中文名称 | 增殖细胞核抗原抗体 |
| 英文别名 | Cyclin; DNA polymerase delta auxiliary protein; HGCN8729; MGC8367; Mutagen-sensitive 209 protein; Pcna/cyclin; PCNAR; Polymerase delta accessory protein; Proliferating Cell Nuclear Antigen; PCNA_HUMAN. |
| 产品应用 | WB=1:500-2000, IHC-P=1:100-500, IHC-F=1:100-500, IF=1:100-500 Not yet tested in other applications. |
| 交叉反应 | Human, Mouse, Rat |
| 抗体来源 | Rabbit |
| 免疫原 | Recombinant human PCNA |
| 亚型 | IgG |
| 性状 | Liquid |
| 纯化方法 | affinity purified by Protein A |
| 克隆类型 | Polyclonal |
| 理论分子量 | 29 kDa |
| 浓度 | 1mg/ml |
| 储存液 | 0.01M TBS (pH7.4) with 1% BSA, 0.02% Proclin300 and 50% Glycerol. |
| 研究领域 | Cancer > Cell cycle > Cell division Cancer > Tumor biomarkers > Tumor antigens Cell Biology > Cell Cycle > Markers Epigenetics and Nuclear Signaling > Chromatin Binding Proteins > DNA / RNA binding Epigenetics and Nuclear Signaling > DNA / RNA > DNA Synthesis Epigenetics and Nuclear Signaling > DNA methylation > Methylated DNA Binding Isotype/Loading Controls > Loading Controls > PCNA Tags & Cell Markers > Cell Type Markers > Replication |
| 亚基 | Homotrimer (PubMed:24939902). |
| 亚细胞定位 | Nucleus. Note=Forms nuclear foci representing sites of ongoing DNA replication and vary in morphology and number during S phase. Together with APEX2, is redistributed in discrete nuclear foci in presence of oxidative DNA damaging agents. |
| 翻译后修饰 | Following DNA damage, can be either monoubiquitinated to stimulate direct bypass of DNA lesions by specialized DNA polymerases or polyubiquitinated to promote recombination-dependent DNA synthesis across DNA lesions by template switching mechanisms. Following induction of replication stress, monoubiquitinated by the UBE2B-RAD18 complex on Lys-164, leading to recruit translesion (TLS) polymerases, which are able to synthesize across DNA lesions in a potentially error-prone manner. An error-free pathway also exists and requires non-canonical polyubiquitination on Lys-164 through 'Lys-63' linkage of ubiquitin moieties by the E2 complex UBE2N-UBE2V2 and the E3 ligases, HLTF, RNF8 and SHPRH. This error-free pathway, also known as template switching, employs recombination mechanisms to synthesize across the lesion, using as a template the undamaged, newly synthesized strand of the sister chromatid. Monoubiquitination at Lys-164 also takes place in undamaged proliferating cells, and is mediated by the DCX(DTL) complex, leading to enhance PCNA-dependent translesion DNA synthesis. Sumoylated during S phase. |
| 相似性 | Belongs to the PCNA family. |
| 功能 | Auxiliary protein of DNA polymerase delta and epsilon, is involved in the control of eukaryotic DNA replication by increasing the polymerase's processibility during elongation of the leading strand (PubMed:35585232). |
| 保存条件 | Shipped at 4℃. Store at -20℃ for one year. Avoid repeated freeze/thaw cycles. |
| 注意事项 | This product as supplied is intended for research use only, not for use in human, therapeutic or diagnostic applications. |
| 背景资料 | Proliferating cell nuclear antigen (PCNA) is a 28kDa nuclear protein associated with the cell cycle, a nuclear protein vital for cellular DNA synthesis. Proliferating cell nuclear antigen was originally identified by immunofluorescence as a nuclear protein whose appearance correlated with the proliferate state of the cell. PCNA is required for replication of DNA in vitro and has been identified as the auxiliary protein (cofactor) for DNA polymerase delta. The anti-PCNA antibodies react with the nuclei of proliferating cells. PCNA is essential for cellular DNA synthesis and is also required for the in vitro replication of simian virus 40 (SV40) DNA where it acts to coordinate leading and lagging strand synthesis at the replication fork. The PCNA protein may fulfil several separate roles in the cell nucleus associated with changes in its antigenic structure. |
| 应用 | 推荐稀释比例 |
| {WB} | {1:500-2000} |
| {IHC-P} | {1:100-500} |
| {IHC-F} | {1:100-500} |
| {IF} | {1:100-500} |

风险提示:丁香通仅作为第三方平台,为商家信息发布提供平台空间。用户咨询产品时请注意保护个人信息及财产安全,合理判断,谨慎选购商品,商家和用户对交易行为负责。对于医疗器械类产品,请先查证核实企业经营资质和医疗器械产品注册证情况。
 技术资料
技术资料暂无技术资料 索取技术资料





